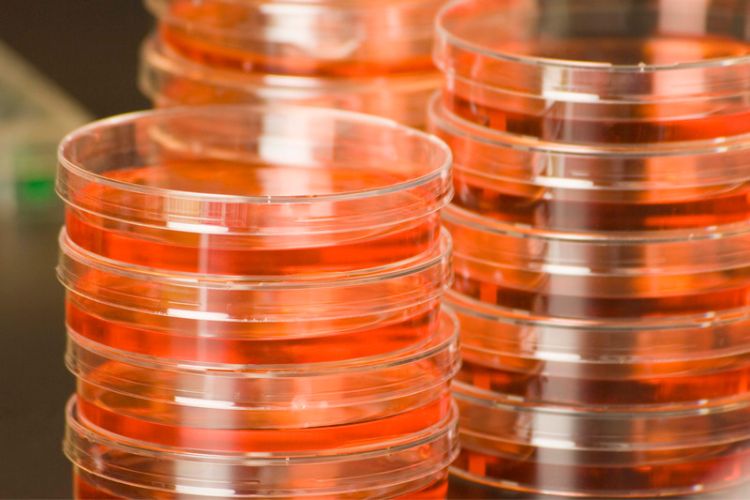
petri dish sistemas logisticos de america

Logística Farmacéutica
Entendemos la importancia de un socio confiable para entregar productos de salud. Por esto es que hemos diseñado soluciones de cadena de suministro para asegurar el transporte de productos sensibles al tiempo de traslado y temperatura implementando servicios de manejo especial y monitoreo.
Con el uso de tecnología de vanguardia respondemos y nos adaptamos a los continuos retos que la industria de la salud tiene que vencer debido a un entorno cambiante.
La confiabilidad es crucial para cumplir los requerimientos de manufactura de productos farmacéuticos, biotecnológicos y médicos. Sabemos las situaciones que pueden poner en riesgo la vida como resultado de productos dañados durante el envío debido a controles deficientes de tiempo y temperatura.
Es por esto que nos aseguramos que los productos sensibles lleguen seguros a su destino. A través del control de calidad y la atención a detalle en el manejo, salvaguardamos la integridad de tus productos preservando su calidad inicial hasta el final de su trayecto.